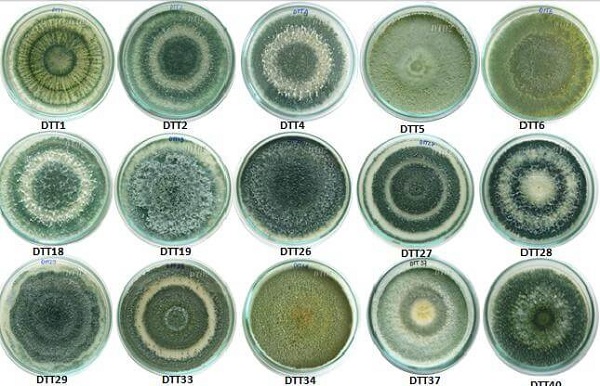

Ngày xưa, khi khoa học chưa phát triển, sau khi thu hoạch lúa sau, còn rơm rạ, bà con nông dân thường đem đi đốt hoặc sử dụng làm các vật dụng trong nhà. Tuy nhiên, ngày nay, do sử dụng hóa chất trong quá trình trồng lúa vì thế mà rơm rạ không còn an toàn. Nếu như đem đốt thì sẽ gây ô nhiễm môi trường. Vì thế mà nhiều người chuyển sang sử dụng chế phẩm sinh học có chứa trichoderma giúp phân hủy và xử lý rơm rạ. Hãy cùng phanthuocvisinh.com tìm hiểu Quy trình xử lý rơm rạ bằng Trichoderma qua bài viết dưới đây nhé!
Contents
Trichoderma là một loại nấm cư trú trong rễ cây và được chuyển hóa thành chế phẩm vi sinh. Loại nấm này có thể tiết ra các enzym loại bỏ các loại nấm nguy hiểm khác. Những loại nấm này tiết ra các chất hóa học phá vỡ thành tế bào của nấm nguy hiểm, tiêu diệt chúng, và cuối cùng phân hủy chúng thành thức ăn. Quá trình này giúp tạo ra các chất hữu cơ ích.
Trichoderma là một loại nấm có khoảng 33 loài, và chúng sinh sản vô tính. Chúng sẽ nhanh chóng nhân lên từ một cá thể thành nhiều cá thể khác. Chúng phát triển tốt nhất ở nhiệt độ từ 25 đến 30 độ C. Loại nấm này có thể sống trong hoàn cảnh tối ưu khoảng một năm rưỡi. Chúng bị chết do nắng quá gắt hoặc mưa kéo dài.
Nấm Trichoderma có công dụng rất lớn trong nông lâm nghiệp. Dưới đây là một số công dụng của loại nấm này.
– Tiêu diệt các loại nấm gây hại cho rễ cây, chẳng hạn như Rhizoctonia solani, Fusarium solani, Phytophthora, và Sclerotium rolfsii,.. nhờ vào đặc tính của nó.
– Loại nấm này còn có khả năng phân hủy mùn và xác thực vật. Nó có thể được sử dụng để thay thế các vi khuẩn gây thối. Quá trình này cũng tạo ra các hóa chất dễ hấp thụ như chitinase, protease, pectinase và các chất khác.

– Đẩy nhanh và giảm mùi trong suốt quá trình ủ phân. Nó có thể được sử dụng trong nhiều loại phân, bao gồm phân chuồng, phân xanh và phân cá.
– Tăng vi sinh vật hữu ích trong đất, làm tơi xốp đất và loại bỏ tuyến trùng gây hại rễ. Nấm Trichoderma là một phương pháp điều trị tuyệt vời đối với tuyến trùng và các bệnh nhiễm nấm.
– Kích thích bộ rễ phát triển, hỗ trợ phục hồi bộ rễ, giúp rễ ăn sâu và vươn xa dễ dàng hấp thụ dinh dưỡng.
– Phân hủy cellulose mạnh. Hỗ trợ sự cân bằng của hệ vi sinh đất
– Trichoderma kết hợp với phân hữu cơ giúp cải tạo đất, tơi xốp và tăng độ phì nhiêu cho đất.
– Giúp tăng sức đề kháng để đồng ruộng khỏi các loại côn trùng tấn công như: bọ trĩ gây hại lúa, nhện đỏ, rệp sáp, sâu xanh cắn phá lá,…
– Cân bằng độ pH và giải độc đất.
– Hỗ trợ trong việc bảo vệ phân bón và chất dinh dưỡng thực vật. Trichoderma sẽ là một cách tiếp cận hiệu quả để tăng hiệu quả sử dụng phân bón cho cây trồng.
– Để đối kháng với nấm bệnh: Phun ướt toàn bộ lá, thân và xung quanh gốc cây bằng bột nấm trichoderma hòa tan trong nước.
– Sử dụng để trừ tuyến trùng: Để sử dụng thuốc diệt tuyến trùng hiệu quả, hãy rắc thuốc vào đất xung quanh gốc cây hoặc kết hợp với nước để tưới vào gốc cây.
– Trộn nấm Trichoderma với giá thể trồng cây: Trộn chế phẩm có chứa trichoderma với giá thể tăng trưởng như đất sinh học, đất thịt, phân hữu cơ,… rồi cho vào khay chậu để trồng cây.
Để xử lý rơm xạ thì bà con có thể chọn cách phân hủy hoặc xử lý bằng các chế phẩm sinh học có chứa trichoderma.
Phân hủy rơm rạ chưa bao giờ dễ dàng hơn với chế phẩm sinh học chứa nấm trichoderma – AT Xử lý rơm rạ 250g và rất phù hợp với cả các khu vực lớn hoặc nhỏ. Với AT xử lý rơm rạ, bà con không cần thu hay gom rơm rạ lại thành một đống mà chỉ cần để nguyên rơm rạ trên ruộng. Sau đó là sử dụng chế phẩm sinh học AT xử lý rơm rạ.
AT xử lý rơm rạ có thành phần chính là nấm trichoderma phân hủy rơm rạ cùng với các loại chất hữu cơ và hàng tỷ vi sinh vật hữu ích, có lợi khác. Vì thế ngoài việc phân hủy rơm rạ, chế phẩm trichoderma phân hủy rơm rạ còn cung cấp chất dinh dưỡng cho đất, hạ phèn bung rễ – ra rễ nhanh.
Chế phẩm hủy rơm rạ có thể bón thẳng vào gốc hoặc kết hợp với các loại phân bón khác dùng để bón lót hoặc bón thúc. Sau 7-10 ngày dùng chế phẩm rơm rạ sẽ bị phân hủy.
Với AT Bio Decomposer 500ml thì bà con có thể trực tiếp xử lý rơm rạ bằng trichoderma ngay trên đồng ruộng hoặc có thể gom lại thành đống rồi phân hủy.
Chế phẩm sinh học này có chứa đến 11 loại vi sinh vật trong đó có nhiều thuộc thuộc chi trichoderma.
Chế phẩm sinh học xử lý rơm rạ này sẽ xử lý nhanh chỉ từ 7 đến 10 ngày. Chống ngộ độc hữu cơ, thối rữa nhanh, tiết kiệm phân bón, tăng năng suất và giảm côn trùng
Xử lý các vật liệu hữu cơ ngay tại chỗ, chẳng hạn như rơm rạ, trấu, mùn cưa, lá cây, phụ phẩm nông nghiệp, xác động vật, phân gia súc, chất thải, v.v. hoặc đánh đống ủ nhờ quá trình cho lên men tích cực để tạo thành phân hữu cơ có giá trị dinh dưỡng cao cho cây trồng.

Với cách phun trực tiếp:
– Bước 1: Chuẩn bị hỗn hợp và phun
Đối với 1 sào Bắc Bộ, hòa tan 200ml chế phẩm trong bình phun (16-18 lít) và phun đều khắp gốc rạ (360m2)
– Bước 2: Cày rơm và vùi lấp
Sau khi phun sản phẩm, dùng máy cày quay gốc rơm rạ, đảm bảo rơm được cày hết vào đất. Sau đó, cho nước ngập mặt ruộng khoảng 4-5cm và san phẳng mặt ruộng bằng máy xới thủ công.
– Bước 3: Hoàn tất
Sau đó, để đất trống 7-10 ngày rồi mới tiến hành gieo cấy định kỳ cho vụ sau.
Với cách ủ phân theo đống:
– Lớp thứ nhất bao gồm một dải rác thực vật ướt (rơm, rạ,…) lần lượt (khoảng 250kg); tiếp theo là 50kg phân chuồng hoai mục, 250g urê, 250g vôi sống và 50ml chế phẩm AT Bio-Decomposer (pha 50ml / 5 lít nước).
– Lớp thứ 2: lấp đầy dải thứ nhất bằng mảnh vụn thực vật đã được làm ẩm (rơm, rạ, v.v.) (khoảng 250kg); Sau đó phủ khoảng 50kg phân chuồng hoai mục, 250g urê, 250g vôi sống và 50ml AT Bio-Decomposer (pha 50ml / 5 lít nước).
Nấm Trichoderma là loại nấm có lợi, chúng có rất nhiều công dụng khác nhau trong nền nông nghiệp. Và một trong số đó chính là phân hủy và xử lý xác tàn dư thực vật như lá khô, rơm rạ,…
Ngoài sản phẩm trị rơm rạ dư trên đồng ruộng Trichoderma, thì kỹ sư tại AT đã nghiên cứu và phát triển ra rất nhiều các sản phẩm thuốc sinh học giúp hỗ trợ bà con trong quá trình canh tác đồng ruộng như: thuốc xử lý lúa lẫn, thuốc giúp vô gạo nhanh, thuốc bung rễ mạnh, giúp rễ bám đất hơn,…
Hy vọng qua bài viết này, bà con nông dân đã biết cách xử lý rơm rạ bằng trichoderma vừa an toàn vừa hiệu quả. Để mua các chế phẩm xử lý rơm rạ, vui lòng liên hệ CÔNG TY TNHH CÔNG NGHỆ SẠCH NÔNG NGHIỆP. Mời bà con cùng đón đọc những thông tin mới nhất được AT cập nhật liên tục tại website: phanthuocvisinh nhé!
Giỏ hàng của bạn hiện tại chưa có sản phẩm nào.